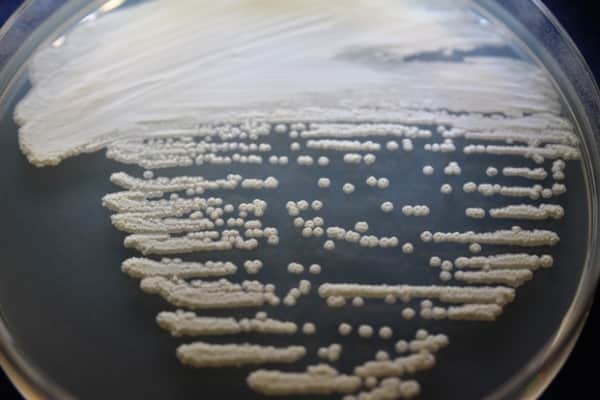

Pichia Membranifaciens
| Use attributes for filter ! | |
| Scientific name and meaning | Pichia membranifaciens |
|---|---|
| Rank | Species |
| Order | Saccharomycetales |
| Famili | Pichiaceae |
| Divis | Ascomycota |
| Kingdom | Fungi |
| Date of Reg. | |
| Date of Upd. | |
| ID | 4040282 |
About Pichia Membranifaciens
Pichia membranifaciens is a species of yeast.